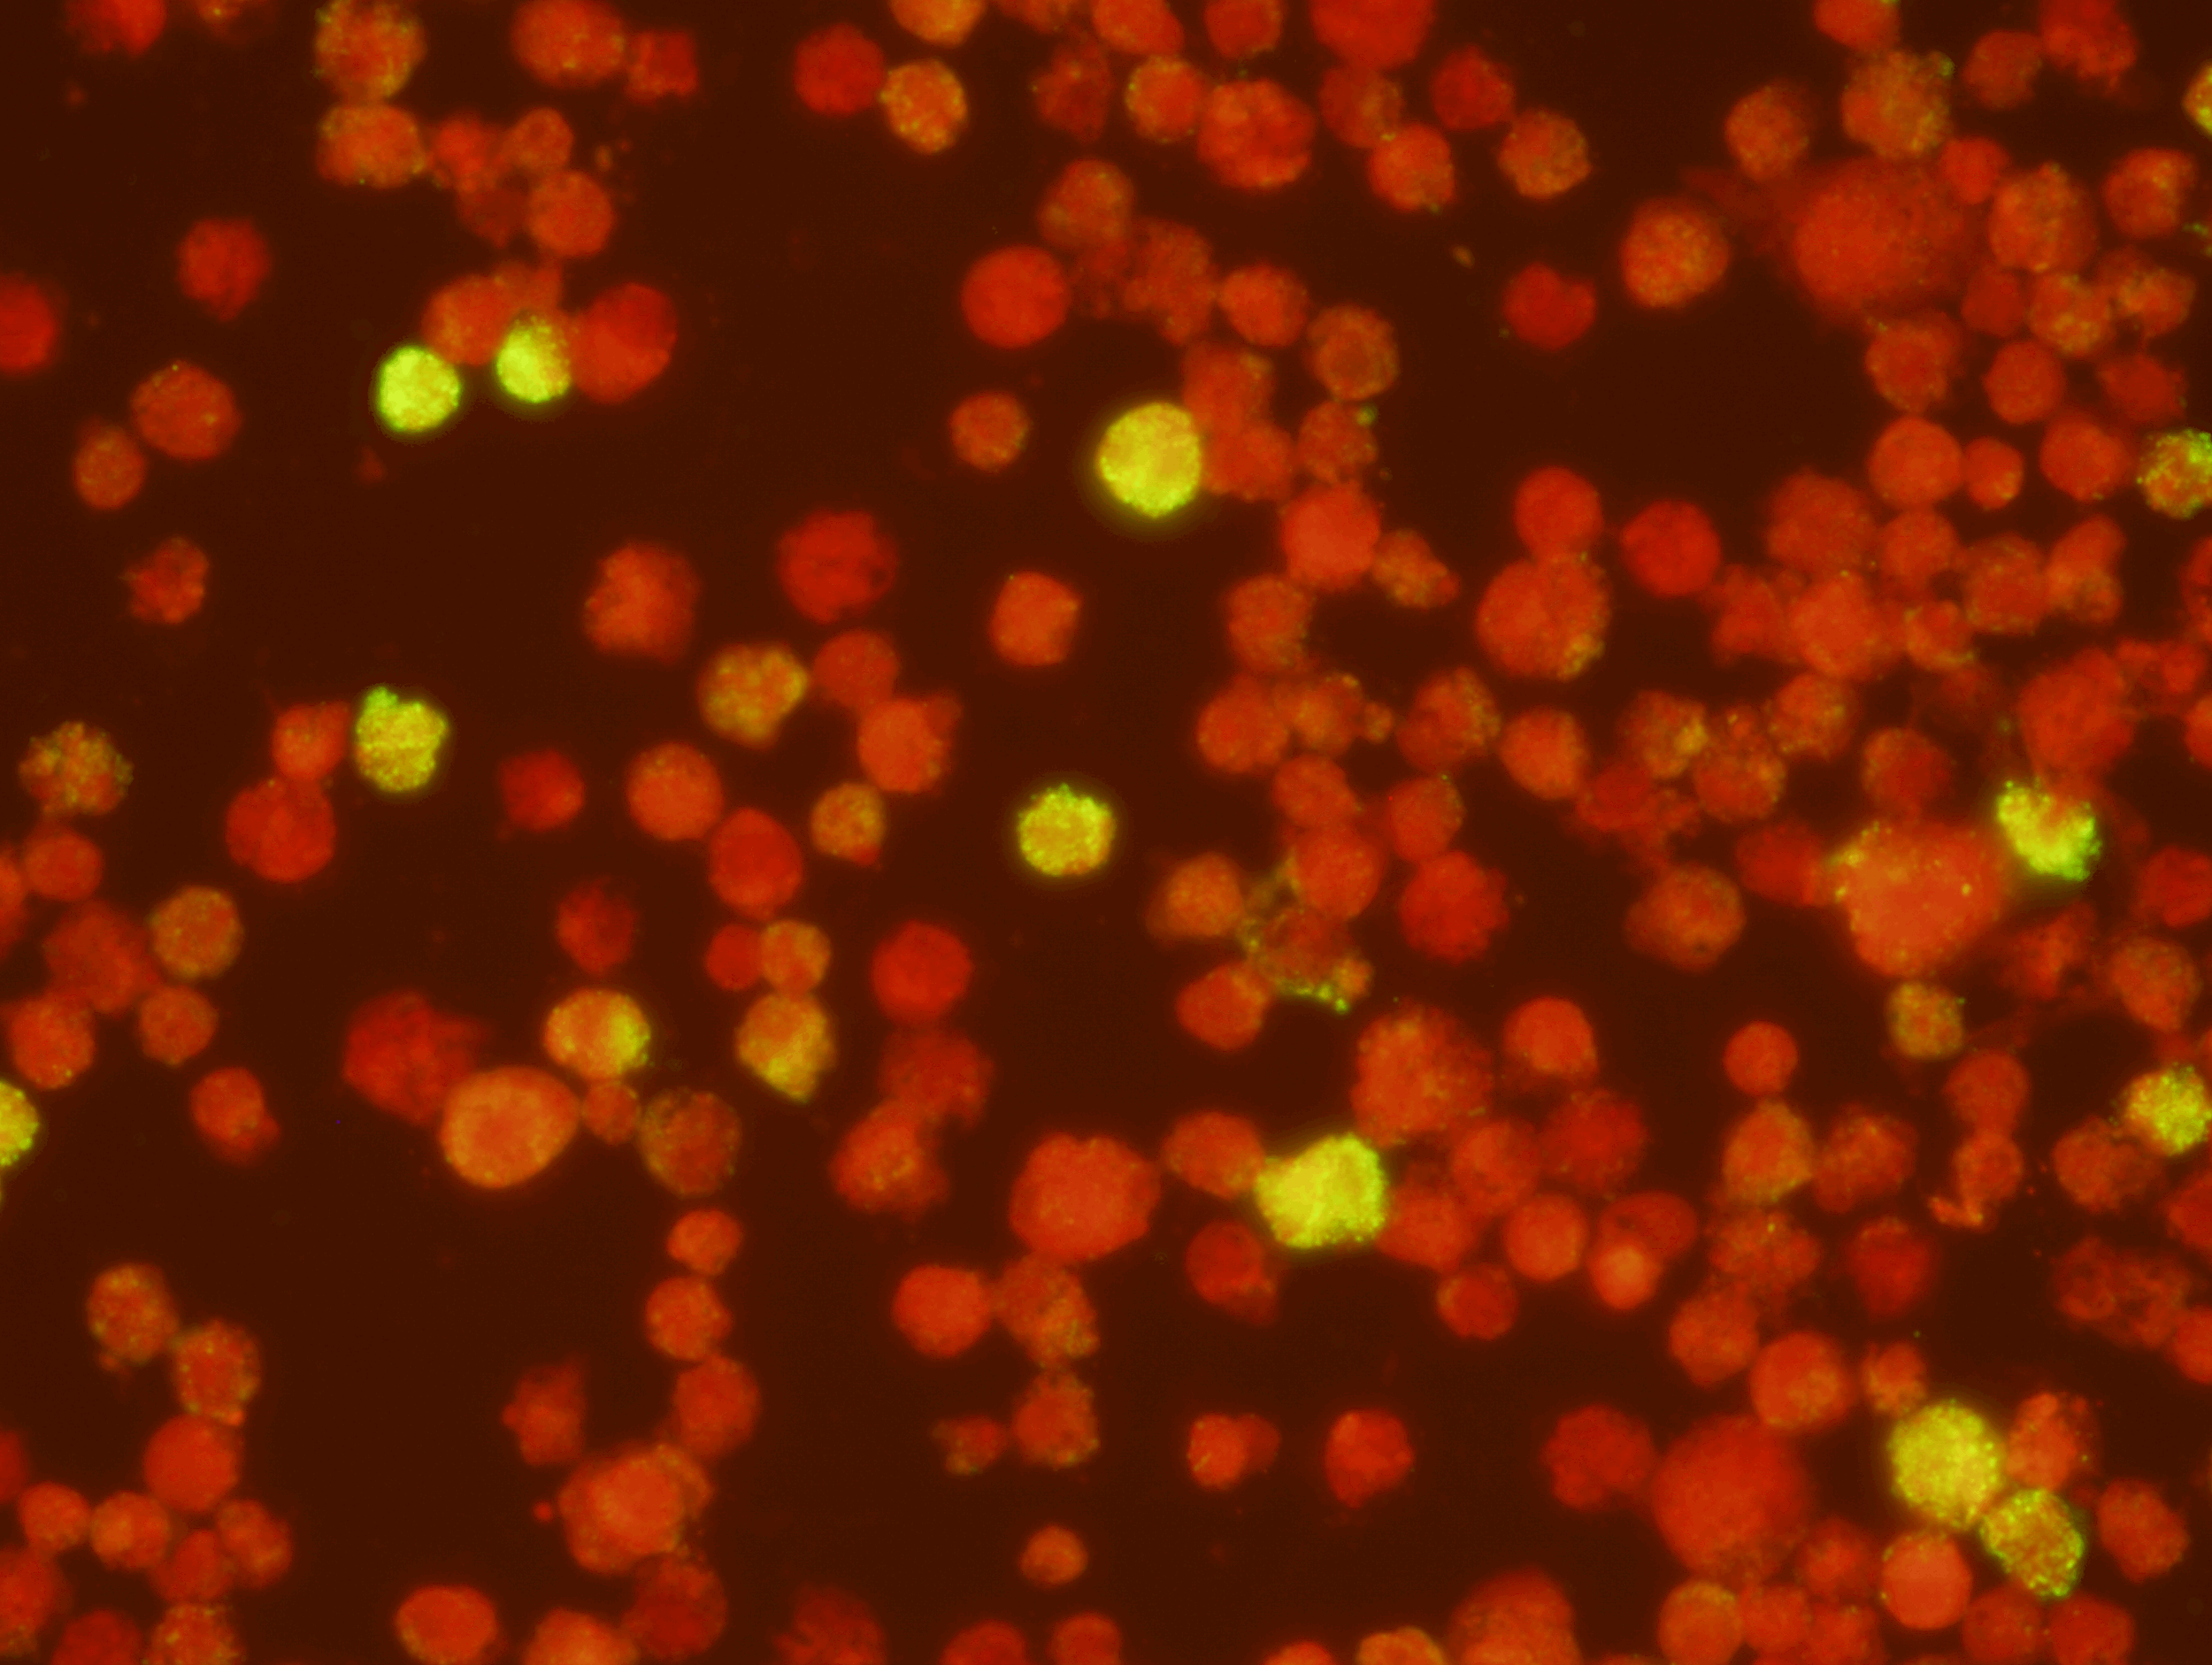
Epstein-Barr Virus (VCA) IgM Test Kit ( Export Only)  Intended for the qualitative and semi-quantitative detection of IgM antibody to Epstein-Barr Virus-Viral Capsid Antigen (EBV-VCA in human serum or plasma. This test can be used as an aid in the
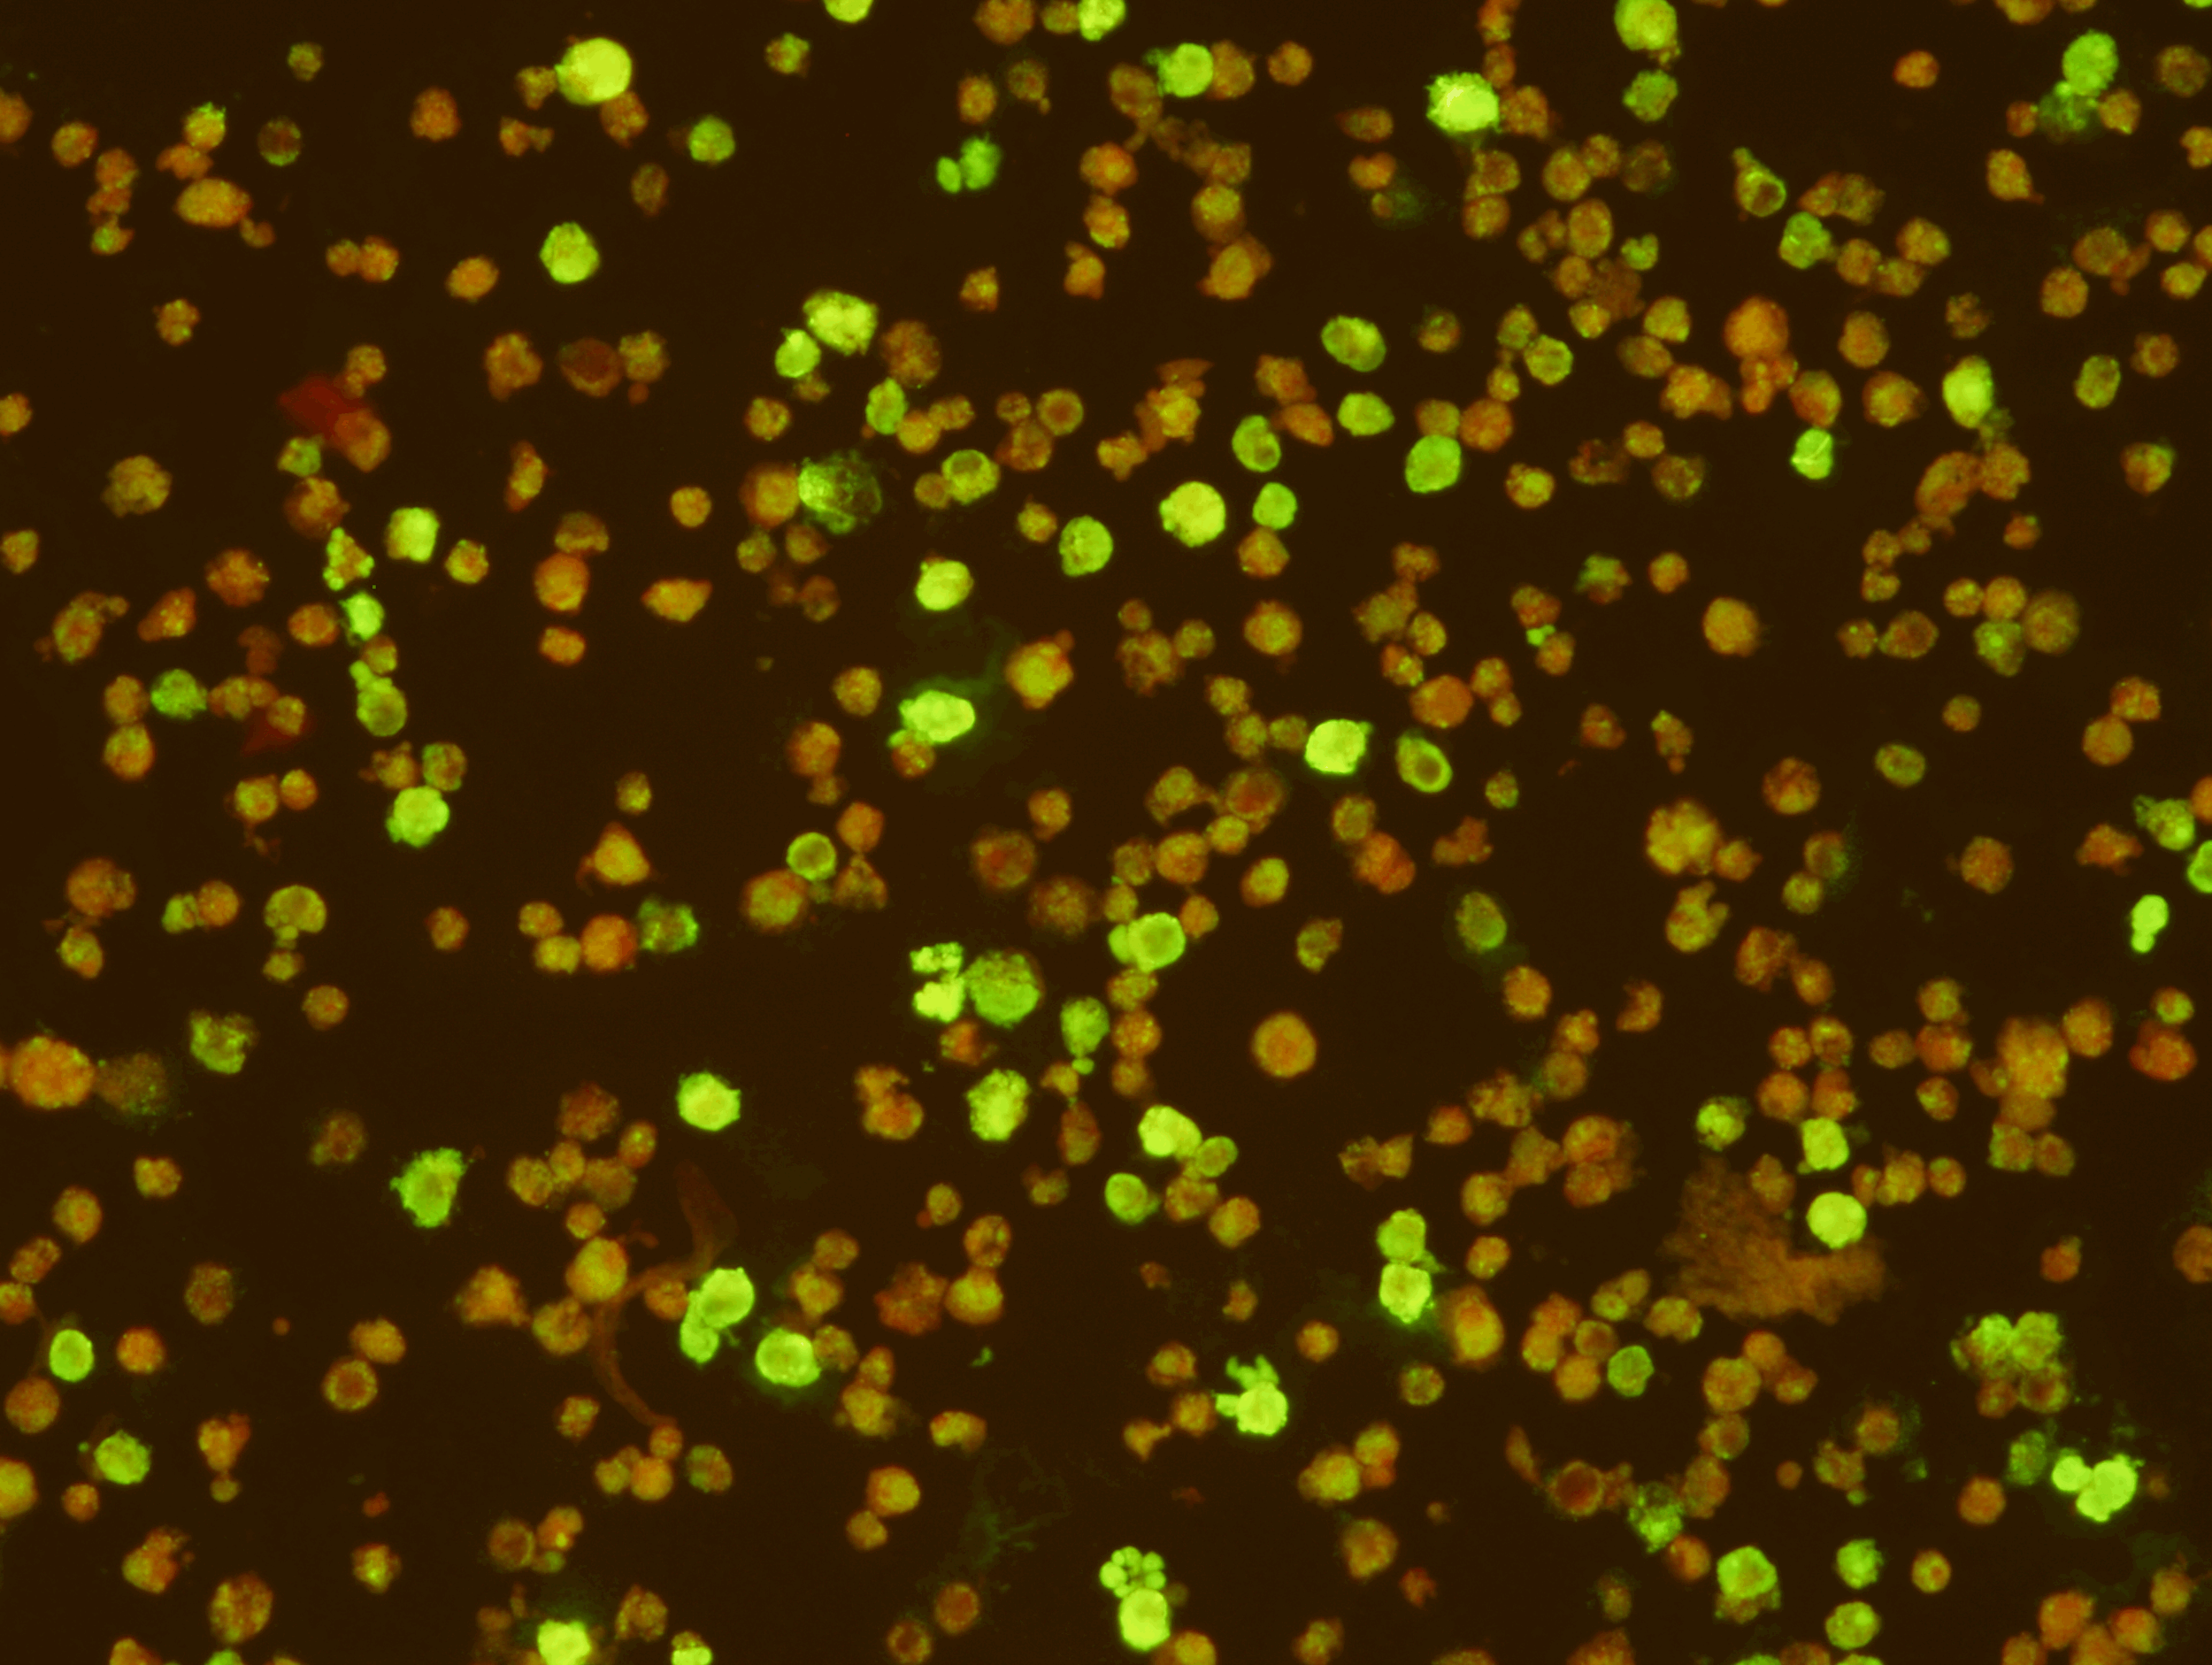
Epstein Barr Virus Early Antigen Test Kit   (Export Only)  Intended for the qualitative and semi-quantitative detection of IgG antibody to the early antigen complex of the Epstein-Barr virus in human serum. The EBV-EA IFA Test Kit should be used in

SCIMEDX CORPORATION is a highly flexible diagnostic company, with over 35 years experience in the area of In Vitro Diagnostics. The strength of the organization is the collective diversified experiences of the personnel in many areas of diagnostics and biochemistry. We specialize in immunofluorescence, ELISA and membrane technologies for a variety of unique and routine autoimmune and infectious diseases. Scimedx combines product development, manufacturing and distribution with a keen awareness of laboratories needs.